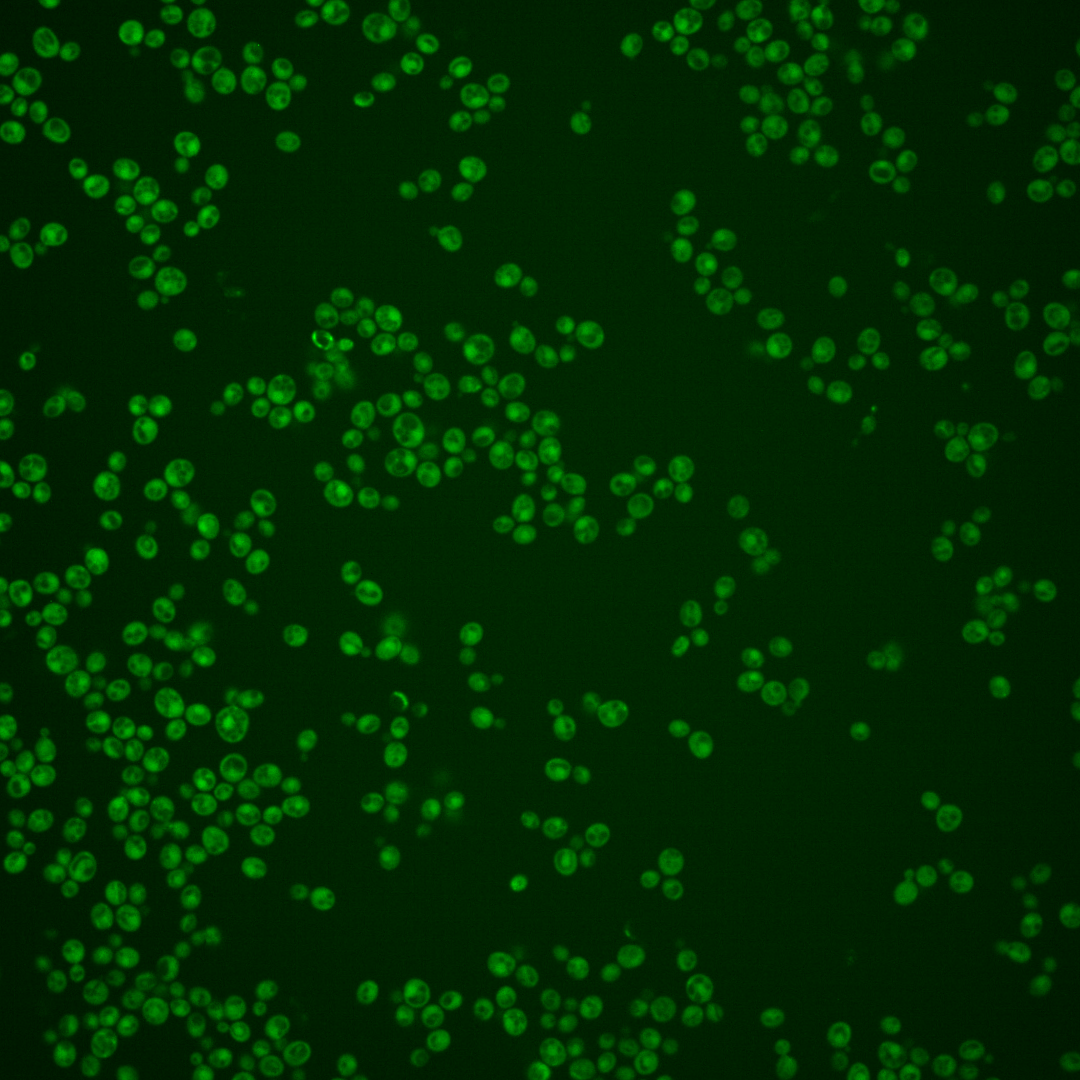
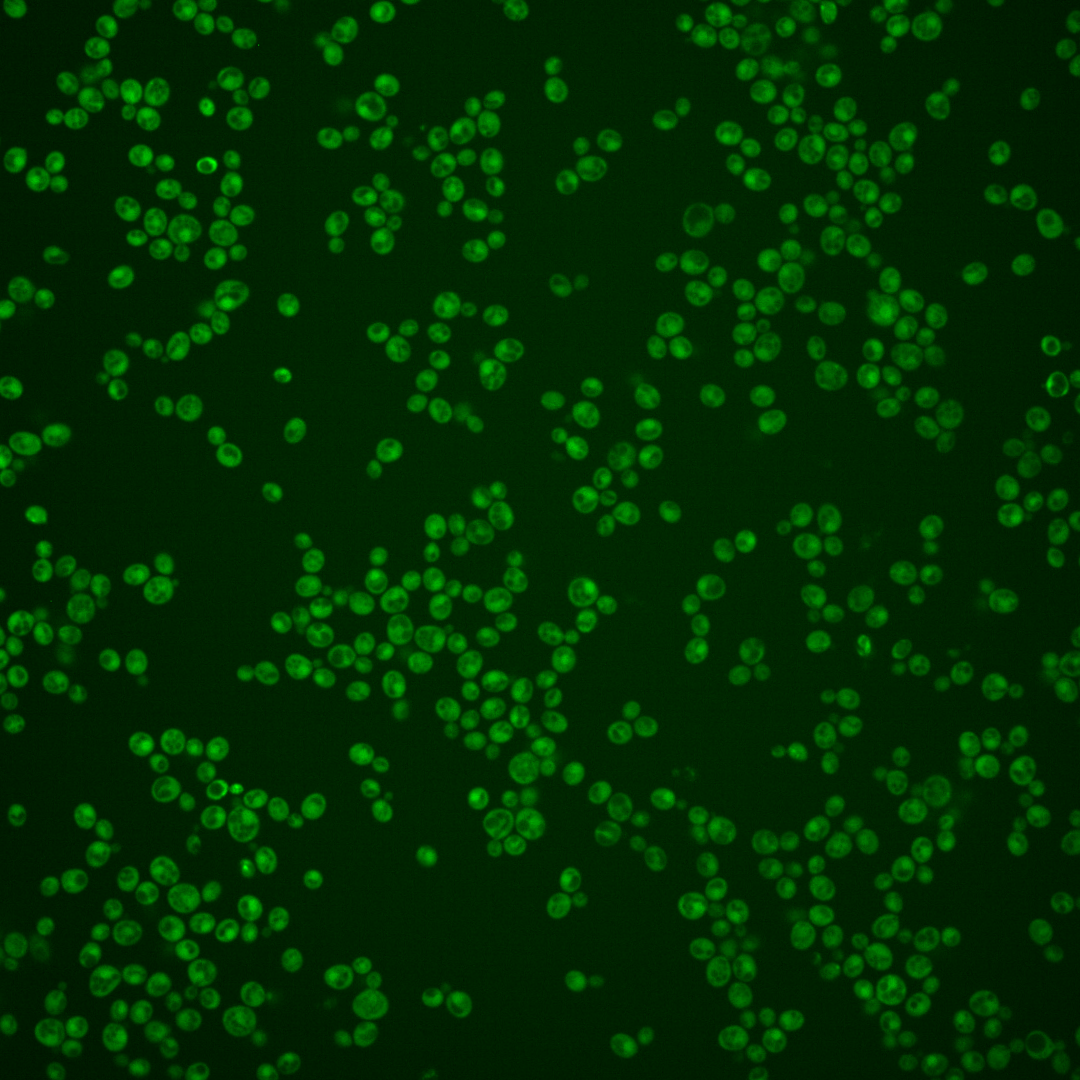
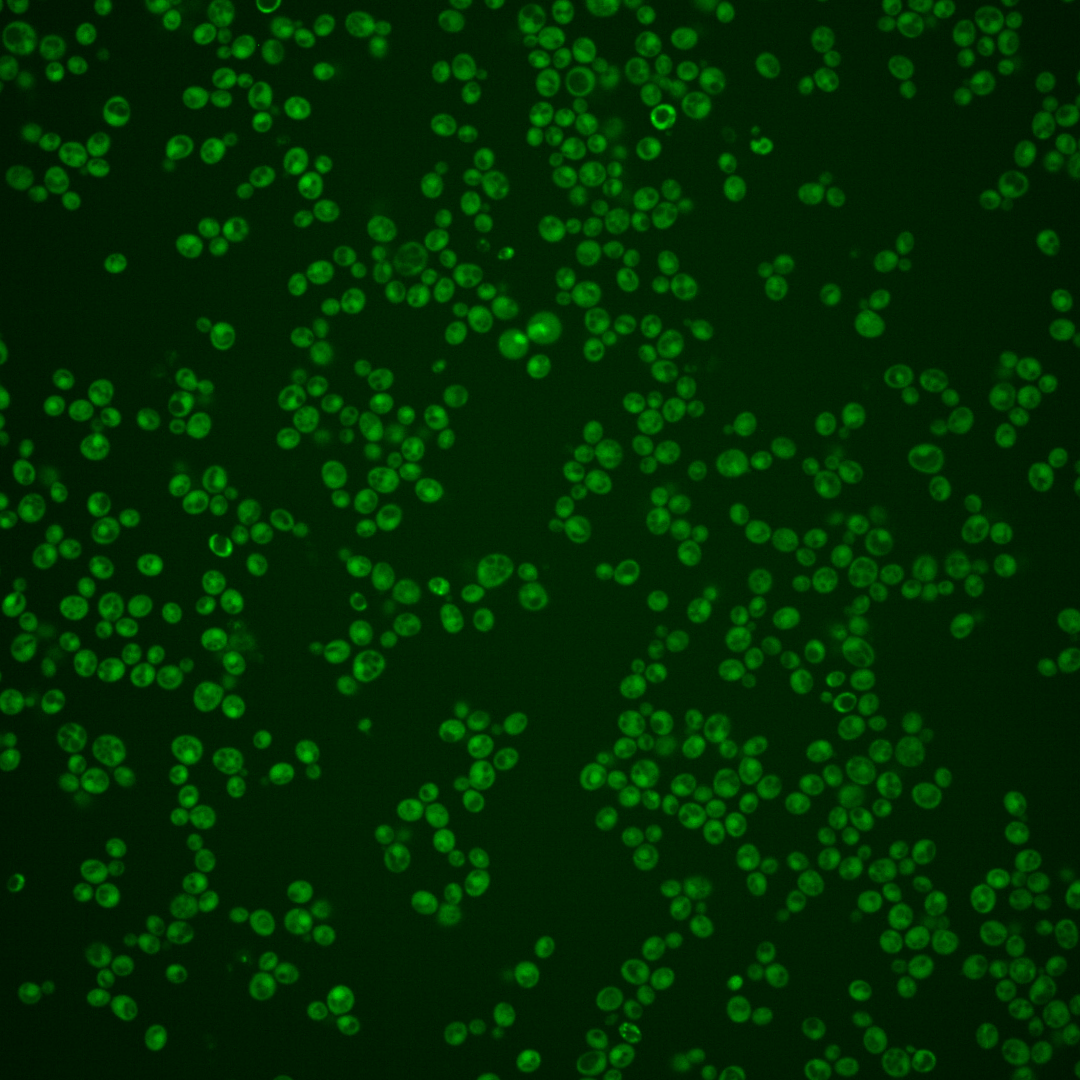

| Standard name | |
|---|---|
| Human Ortholog | |
| Description | Beta subunit of geranylgeranyltransferase type I; subunit of the Ram2p-Cdc43p heterodimer that catalyzes the geranylgeranylation of the cysteine residue in proteins containing a C-terminal CaaX sequence ending in Leu or Phe; has substrates important for morphogenesis |
Micrographs




















































































Sub-cellular Localization
Yeast GFP Assignment
Protein Abundance
Localization Change
External localization resources
| ensLOC | DeepLoc | |||||||||||||||||||||||
|---|---|---|---|---|---|---|---|---|---|---|---|---|---|---|---|---|---|---|---|---|---|---|---|---|
| Localization | WT1 | WT2 | WT3 | RAP60 | RAP140 | RAP220 | RAP300 | RAP380 | RAP460 | RAP540 | RAP620 | RAP700 | HU80 | HU120 | HU160 | rpd3Δ_1 | rpd3Δ_2 | rpd3Δ_3 | WT1 | WT2 | WT3 | AF100 | AF140 | AF180 |
| Cortical Patches | 0 | 0 | 0 | 0 | 0 | 0 | 0 | 0 | 0 | 1 | 0 | 0 | 0 | 0 | 0 | 0 | 0 | 0 | 2 | 0 | 1 | 1 | 2 | 5 |
| Bud | 1 | 1 | 0 | 0 | 1 | 0 | 3 | 6 | 10 | 7 | 10 | 9 | 0 | 0 | 0 | 0 | 0 | 0 | 2 | 0 | 1 | 6 | 8 | 20 |
| Bud Neck | 0 | 0 | 1 | 0 | 1 | 0 | 1 | 0 | 0 | 5 | 0 | 0 | 0 | 1 | 0 | 0 | 0 | 0 | 0 | 0 | 0 | 0 | 2 | 5 |
| Bud Site | 0 | 0 | 0 | 0 | 0 | 0 | 0 | 0 | 0 | 0 | 1 | 1 | 0 | 0 | 0 | 0 | 0 | 0 | – | – | – | – | – | – |
| Cell Periphery | 1 | 1 | 2 | 2 | 3 | 4 | 4 | 3 | 2 | 3 | 0 | 3 | 1 | 1 | 0 | 6 | 7 | 5 | 0 | 0 | 0 | 0 | 0 | 1 |
| Cytoplasm | 449 | 264 | 320 | 331 | 430 | 395 | 392 | 446 | 323 | 400 | 292 | 276 | 341 | 425 | 485 | 206 | 166 | 177 | 486 | 255 | 323 | 354 | 503 | 532 |
| Endoplasmic Reticulum | 1 | 1 | 4 | 0 | 1 | 0 | 0 | 2 | 1 | 1 | 1 | 0 | 0 | 0 | 0 | 5 | 6 | 3 | 0 | 0 | 1 | 1 | 3 | 8 |
| Endosome | 3 | 0 | 0 | 0 | 2 | 0 | 0 | 1 | 0 | 0 | 0 | 0 | 0 | 1 | 1 | 2 | 1 | 2 | 3 | 2 | 0 | 2 | 2 | 1 |
| Golgi | 1 | 0 | 0 | 0 | 2 | 0 | 0 | 0 | 0 | 0 | 0 | 0 | 0 | 1 | 0 | 2 | 1 | 2 | 1 | 0 | 0 | 1 | 0 | 2 |
| Mitochondria | 3 | 1 | 1 | 6 | 24 | 80 | 130 | 122 | 182 | 127 | 232 | 122 | 0 | 1 | 0 | 4 | 4 | 2 | 2 | 4 | 5 | 2 | 5 | 5 |
| Nucleus | 3 | 1 | 0 | 1 | 0 | 3 | 5 | 13 | 7 | 10 | 8 | 5 | 0 | 0 | 2 | 3 | 3 | 3 | 3 | 2 | 0 | 0 | 1 | 0 |
| Nuclear Periphery | 2 | 0 | 0 | 1 | 1 | 1 | 0 | 1 | 0 | 1 | 1 | 0 | 0 | 0 | 0 | 0 | 0 | 0 | 1 | 0 | 0 | 0 | 0 | 0 |
| Nucleolus | 1 | 0 | 0 | 0 | 0 | 0 | 1 | 1 | 0 | 0 | 0 | 0 | 0 | 0 | 0 | 0 | 0 | 0 | 0 | 0 | 0 | 1 | 0 | 0 |
| Peroxisomes | 1 | 0 | 0 | 0 | 0 | 0 | 0 | 0 | 0 | 0 | 0 | 0 | 0 | 0 | 1 | 0 | 0 | 0 | 0 | 0 | 0 | 0 | 0 | 0 |
| SpindlePole | 0 | 0 | 0 | 0 | 0 | 0 | 0 | 1 | 1 | 2 | 3 | 1 | 1 | 0 | 0 | 0 | 0 | 0 | 3 | 0 | 1 | 1 | 3 | 9 |
| Vac/Vac Membrane | 15 | 5 | 3 | 12 | 29 | 20 | 26 | 15 | 20 | 20 | 10 | 22 | 33 | 30 | 23 | 19 | 14 | 13 | 2 | 1 | 2 | 2 | 1 | 3 |
| Unique Cell Count | 467 | 268 | 326 | 340 | 463 | 446 | 486 | 537 | 440 | 508 | 435 | 368 | 360 | 440 | 496 | 222 | 179 | 191 | 515 | 272 | 342 | 382 | 544 | 603 |
| Labelled Cell Count | 481 | 274 | 331 | 353 | 494 | 503 | 562 | 611 | 546 | 577 | 558 | 439 | 376 | 460 | 512 | 247 | 202 | 207 | 515 | 272 | 342 | 382 | 544 | 603 |
Yeast GFP Assignment
Protein Abundance
| Screen | WT1 | WT2 | WT3 | RAP60 | RAP140 | RAP220 | RAP300 | RAP380 | RAP460 | RAP540 | RAP620 | RAP700 | HU80 | HU120 | HU160 | rpd3Δ_1 | rpd3Δ_2 | rpd3Δ_3 | AF100 | AF140 | AF180 |
|---|---|---|---|---|---|---|---|---|---|---|---|---|---|---|---|---|---|---|---|---|---|
| Mean Cell GFP Intensity (1e-4) | 5.7 | 7.0 | 6.0 | 5.7 | 5.6 | 4.5 | 4.2 | 4.8 | 3.9 | 4.2 | 3.8 | 4.2 | 6.3 | 6.9 | 6.8 | 7.0 | 7.8 | 7.2 | 6.6 | 6.7 | 7.3 |
| Std Deviation (1e-4) | 0.9 | 1.2 | 0.8 | 1.5 | 1.4 | 1.1 | 1.2 | 1.2 | 1.2 | 1.2 | 1.0 | 1.2 | 1.1 | 1.9 | 1.5 | 1.5 | 1.5 | 1.7 | 1.8 | 1.7 | 2.2 |
| Intensity Change (Log2) | – | – | – | -0.07 | -0.12 | -0.44 | -0.53 | -0.34 | -0.63 | -0.51 | -0.68 | -0.52 | 0.05 | 0.19 | 0.16 | 0.22 | 0.37 | 0.26 | 0.13 | 0.15 | 0.26 |
Localization Change
| Localization | RAP60 | RAP140 | RAP220 | RAP300 | RAP380 | RAP460 | RAP540 | RAP620 | RAP700 | HU80 | HU120 | HU160 | rpd3Δ_1 | rpd3Δ_2 | rpd3Δ_3 |
|---|---|---|---|---|---|---|---|---|---|---|---|---|---|---|---|
| Cortical Patches | 0 | 0 | 0 | 0 | 0 | 0 | 0 | 0 | 0 | 0 | 0 | 0 | 0 | 0 | 0 |
| Bud | 0 | 0 | 0 | 0 | 0 | 0 | 0 | 0 | 0 | 0 | 0 | 0 | 0 | 0 | 0 |
| Bud Neck | 0 | 0 | 0 | 0 | 0 | 0 | 0 | 0 | 0 | 0 | 0 | 0 | 0 | 0 | 0 |
| Bud Site | 0 | 0 | 0 | 0 | 0 | 0 | 0 | 0 | 0 | 0 | 0 | 0 | 0 | 0 | 0 |
| Cell Periphery | 0 | 0 | 0 | 0 | 0 | 0 | 0 | 0 | 0 | 0 | 0 | 0 | 0 | 0 | 0 |
| Cytoplasm | -0.7 | -3.4 | -5.0 | -7.4 | -6.8 | -9.2 | -8.0 | -10.7 | -8.7 | -2.4 | -1.3 | -0.4 | -3.1 | -3.1 | -3.1 |
| Endoplasmic Reticulum | 0 | 0 | 0 | 0 | 0 | 0 | 0 | 0 | 0 | 0 | 0 | 0 | 0 | 0 | 0 |
| Endosome | 0 | 0 | 0 | 0 | 0 | 0 | 0 | 0 | 0 | 0 | 0 | 0 | 0 | 0 | 0 |
| Golgi | 0 | 0 | 0 | 0 | 0 | 0 | 0 | 0 | 0 | 0 | 0 | 0 | 0 | 0 | 0 |
| Mitochondria | 0 | 3.9 | 0 | 0 | 0 | 0 | 0 | 0 | 0 | 0 | 0 | 0 | 0 | 0 | 0 |
| Nucleus | 0 | 0 | 0 | 0 | 0 | 0 | 0 | 0 | 0 | 0 | 0 | 0 | 0 | 0 | 0 |
| Nuclear Periphery | 0 | 0 | 0 | 0 | 0 | 0 | 0 | 0 | 0 | 0 | 0 | 0 | 0 | 0 | 0 |
| Nucleolus | 0 | 0 | 0 | 0 | 0 | 0 | 0 | 0 | 0 | 0 | 0 | 0 | 0 | 0 | 0 |
| Peroxisomes | 0 | 0 | 0 | 0 | 0 | 0 | 0 | 0 | 0 | 0 | 0 | 0 | 0 | 0 | 0 |
| SpindlePole | 0 | 0 | 0 | 0 | 0 | 0 | 0 | 0 | 0 | 0 | 0 | 0 | 0 | 0 | 0 |
| Vacuole | 2.3 | 3.7 | 2.9 | 3.3 | 1.9 | 2.9 | 2.6 | 1.5 | 3.6 | 4.8 | 4.0 | 3.0 | 4.5 | 4.1 | 3.7 |
External localization resources
Images






























Protein Concentration and Protein Localization Data
| R1 | R2 | R3 | ||||||||||||||||
|---|---|---|---|---|---|---|---|---|---|---|---|---|---|---|---|---|---|---|
| G1 Pre-START | G1 Post-START | S/G2 | Metaphase | Anaphase | Telophase | G1 Pre-START | G1 Post-START | S/G2 | Metaphase | Anaphase | Telophase | G1 Pre-START | G1 Post-START | S/G2 | Metaphase | Anaphase | Telophase | |
| Concentration | 1.9516 | 2.6256 | 2.3886 | 2.0349 | 2.2912 | 2.33 | 0.8695 | 1.1909 | 1.074 | 0.5733 | 0.2847 | 1.454 | 0.8895 | 1.4125 | 1.2816 | 1.2603 | 1.1261 | 1.3569 |
| Actin | 0.0148 | 0.0045 | 0.0127 | 0.0012 | 0.0264 | 0.004 | 0.0066 | 0.0003 | 0.0014 | 0.0165 | 0.0015 | 0.0082 | 0.0098 | 0.0002 | 0.0007 | 0.0001 | 0.0032 | 0.0007 |
| Bud | 0.0008 | 0.0025 | 0.006 | 0.0031 | 0.0031 | 0.0004 | 0.0031 | 0.0087 | 0.0053 | 0.0004 | 0.0009 | 0.0035 | 0.0004 | 0.0002 | 0.0003 | 0.0002 | 0.0003 | 0.0004 |
| Bud Neck | 0.0041 | 0.0009 | 0.003 | 0.0004 | 0.0135 | 0.001 | 0.0019 | 0.0002 | 0.0009 | 0.0004 | 0.0201 | 0.0016 | 0.0033 | 0.0002 | 0.0003 | 0.0006 | 0.0016 | 0.0023 |
| Bud Periphery | 0.0011 | 0.0016 | 0.0048 | 0.0157 | 0.0056 | 0.0004 | 0.0018 | 0.0019 | 0.0012 | 0.0008 | 0.0009 | 0.0019 | 0.0002 | 0.0001 | 0.0002 | 0.0001 | 0.0002 | 0.0005 |
| Bud Site | 0.0107 | 0.0102 | 0.0071 | 0.0008 | 0.0173 | 0.0003 | 0.0065 | 0.0067 | 0.0082 | 0.0002 | 0.0137 | 0.0006 | 0.0066 | 0.0019 | 0.0007 | 0.0002 | 0.0008 | 0.0002 |
| Cell Periphery | 0.0003 | 0.0002 | 0.0005 | 0.0001 | 0.0003 | 0.0001 | 0.0003 | 0.0002 | 0.0001 | 0 | 0.0001 | 0.0001 | 0.0002 | 0.0001 | 0 | 0 | 0.0001 | 0 |
| Cytoplasm | 0.4268 | 0.6582 | 0.4928 | 0.5378 | 0.507 | 0.5806 | 0.3752 | 0.5945 | 0.453 | 0.5328 | 0.4933 | 0.5607 | 0.6628 | 0.7043 | 0.6708 | 0.7699 | 0.8057 | 0.7518 |
| Cytoplasmic Foci | 0.0211 | 0.0142 | 0.0117 | 0.0101 | 0.0411 | 0.0166 | 0.0508 | 0.0092 | 0.0211 | 0.0079 | 0.0138 | 0.0179 | 0.0105 | 0.0087 | 0.0082 | 0.0051 | 0.0163 | 0.0104 |
| Eisosomes | 0.0002 | 0.0001 | 0.0004 | 0.0001 | 0.0002 | 0.0001 | 0.0001 | 0 | 0 | 0.0001 | 0 | 0 | 0 | 0 | 0 | 0 | 0 | 0 |
| Endoplasmic Reticulum | 0.0039 | 0.0028 | 0.0024 | 0.0024 | 0.0041 | 0.0022 | 0.0037 | 0.0016 | 0.0018 | 0.0007 | 0.0009 | 0.0019 | 0.0033 | 0.0024 | 0.0021 | 0.0014 | 0.0032 | 0.0021 |
| Endosome | 0.0201 | 0.0067 | 0.0072 | 0.0111 | 0.0198 | 0.0066 | 0.0233 | 0.0014 | 0.0144 | 0.0017 | 0.0017 | 0.0136 | 0.006 | 0.0027 | 0.003 | 0.0023 | 0.0094 | 0.0025 |
| Golgi | 0.0068 | 0.0014 | 0.0026 | 0.0004 | 0.0081 | 0.0012 | 0.0042 | 0.0001 | 0.0023 | 0.0003 | 0.0015 | 0.0024 | 0.0006 | 0.0001 | 0.0002 | 0.0001 | 0.0013 | 0.0001 |
| Lipid Particles | 0.0089 | 0.0005 | 0.0078 | 0.0003 | 0.0093 | 0.0014 | 0.0063 | 0.0002 | 0.004 | 0.0001 | 0.0005 | 0.0059 | 0.0005 | 0.0002 | 0.0001 | 0 | 0.0014 | 0.0001 |
| Mitochondria | 0.0054 | 0.0024 | 0.0098 | 0.0022 | 0.0141 | 0.0017 | 0.0045 | 0.0009 | 0.0016 | 0.0007 | 0.0008 | 0.0012 | 0.0003 | 0.0002 | 0.0004 | 0.0004 | 0.0005 | 0.0003 |
| None | 0.4448 | 0.2525 | 0.3909 | 0.3706 | 0.2724 | 0.3502 | 0.4496 | 0.3611 | 0.4527 | 0.3987 | 0.4374 | 0.3411 | 0.2791 | 0.264 | 0.2816 | 0.1679 | 0.1157 | 0.1881 |
| Nuclear Periphery | 0.007 | 0.003 | 0.0035 | 0.0091 | 0.0053 | 0.0051 | 0.0113 | 0.0009 | 0.0023 | 0.0009 | 0.0008 | 0.0028 | 0.0019 | 0.0013 | 0.0016 | 0.0018 | 0.0026 | 0.0019 |
| Nucleolus | 0.0013 | 0.0009 | 0.001 | 0.0005 | 0.0009 | 0.0003 | 0.0017 | 0.0007 | 0.001 | 0.0001 | 0.0002 | 0.0002 | 0.0002 | 0.0001 | 0.0002 | 0.0002 | 0.0003 | 0.0002 |
| Nucleus | 0.0068 | 0.0167 | 0.0161 | 0.0246 | 0.013 | 0.0188 | 0.0221 | 0.0081 | 0.0126 | 0.0105 | 0.0038 | 0.0165 | 0.0095 | 0.0081 | 0.0245 | 0.0463 | 0.0243 | 0.031 |
| Peroxisomes | 0.0065 | 0.0019 | 0.0047 | 0.0009 | 0.0194 | 0.0014 | 0.013 | 0.0001 | 0.0063 | 0.0247 | 0.006 | 0.0133 | 0.0004 | 0.0002 | 0.0004 | 0.0001 | 0.001 | 0.0005 |
| Punctate Nuclear | 0.0056 | 0.0168 | 0.0127 | 0.0051 | 0.0163 | 0.0064 | 0.0089 | 0.0018 | 0.0063 | 0.0017 | 0.0012 | 0.0049 | 0.003 | 0.0038 | 0.0032 | 0.0017 | 0.0106 | 0.0058 |
| Vacuole | 0.0023 | 0.0017 | 0.0017 | 0.0022 | 0.0021 | 0.0008 | 0.0041 | 0.0012 | 0.003 | 0.0007 | 0.0006 | 0.0012 | 0.0012 | 0.0011 | 0.0012 | 0.0015 | 0.0012 | 0.0009 |
| Vacuole Periphery | 0.0008 | 0.0003 | 0.0006 | 0.0012 | 0.0008 | 0.0004 | 0.001 | 0.0002 | 0.0005 | 0.0001 | 0.0001 | 0.0004 | 0.0002 | 0.0001 | 0.0002 | 0.0002 | 0.0002 | 0.0001 |
Sequencing Data
| R1 | R2 | |||||||||
|---|---|---|---|---|---|---|---|---|---|---|
| G1 Post-START | S/G2 | Metaphase | Anaphase | Telophase | G1 Post-START | S/G2 | Metaphase | Anaphase | Telophase | |
| Gene Expression | 24.39 | 27.9081 | 23.9448 | 25.988 | 34.1525 | 18.5262 | 29.5405 | 21.1282 | 24.2322 | 30.9132 |
| Translational Efficiency | 0.707 | 0.5943 | 0.611 | 0.5733 | 0.3957 | 0.7977 | 0.5221 | 0.6857 | 0.64 | 0.48 |
Hit Data
| Dataset | Hit |
|---|---|
| Protein Concentration | ✘ |
| Protein Localization | ✘ |
| Gene Expression | ✘ |
| Translational Efficiency | ✘ |
Endocytosis
| Temp | Actin Patch (Sac6-tdTomato) | Cortical Patch (Sla1-GFP) | Late Endosome (Snf7-GFP) | Vacuole (Vph1-GFP) |
|---|---|---|---|---|
| 37℃ | ||||
| RT |
Cell Cycle Omics
CYCLoPs (Cdc43-GFP)
| Gene / Allele | Actin Patch (Sac6-tdTomato) | Cortical Patch (Sla1-GFP) | Late Endosome (Snf7-GFP) | Vacuole (Sac6-tdTomato) |
|---|
| Gene | Images |
|---|
| Gene | Images |
|---|
Images are not yet available
Images are not yet available